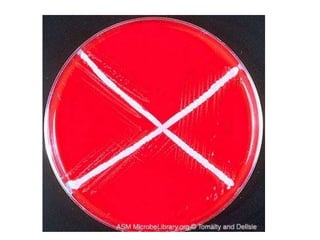

O documento descreve diversos gêneros de bacilos gram-positivos, incluindo Corynebacterium que causam difteria, Listeria que causa meningite em imunocomprometidos, e Bacillus que inclui B. anthracis causador de antraz. Também discute gêneros como Nocardia, agente de infecções pulmonares, e Legionella pneumophila causador da doença dos legionários.